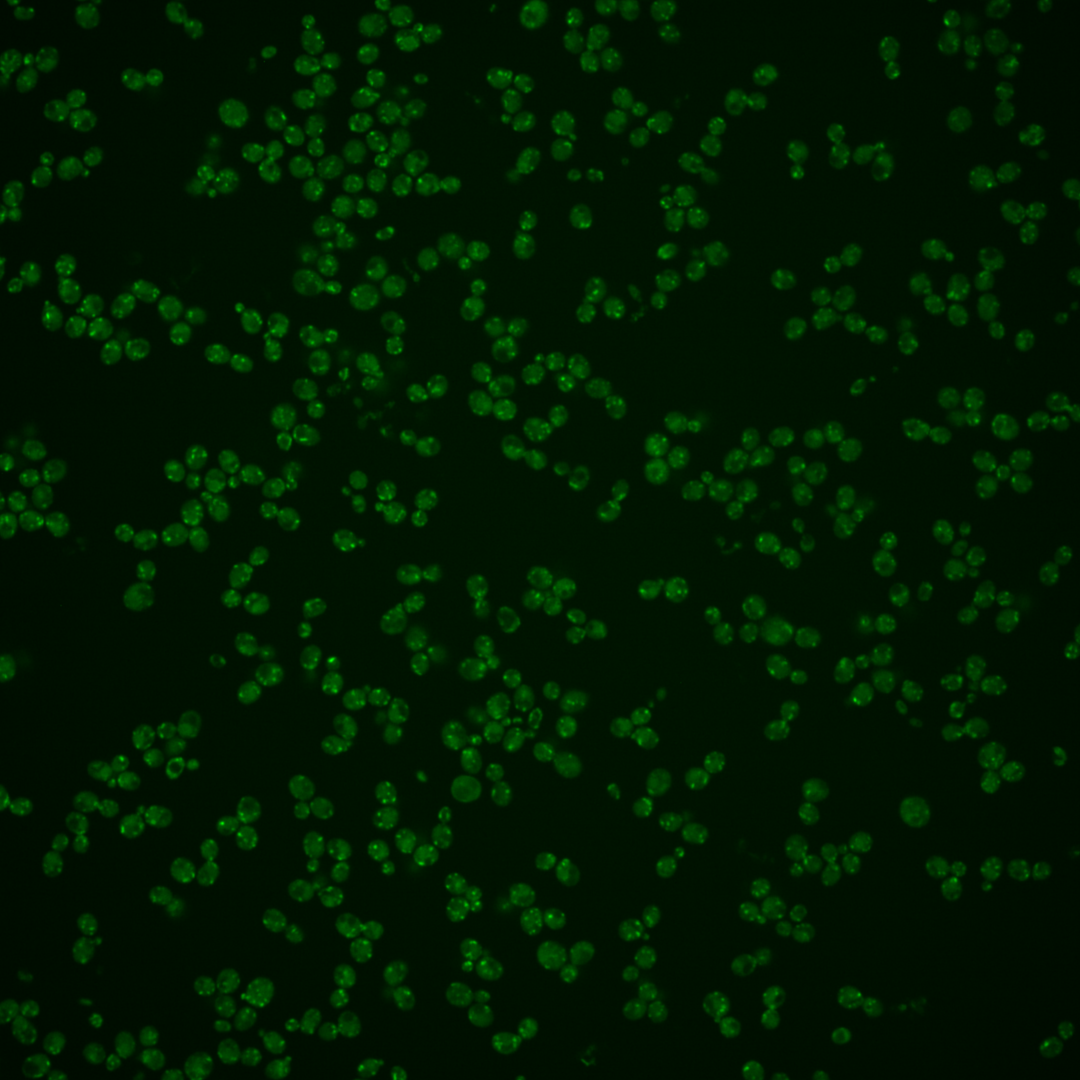
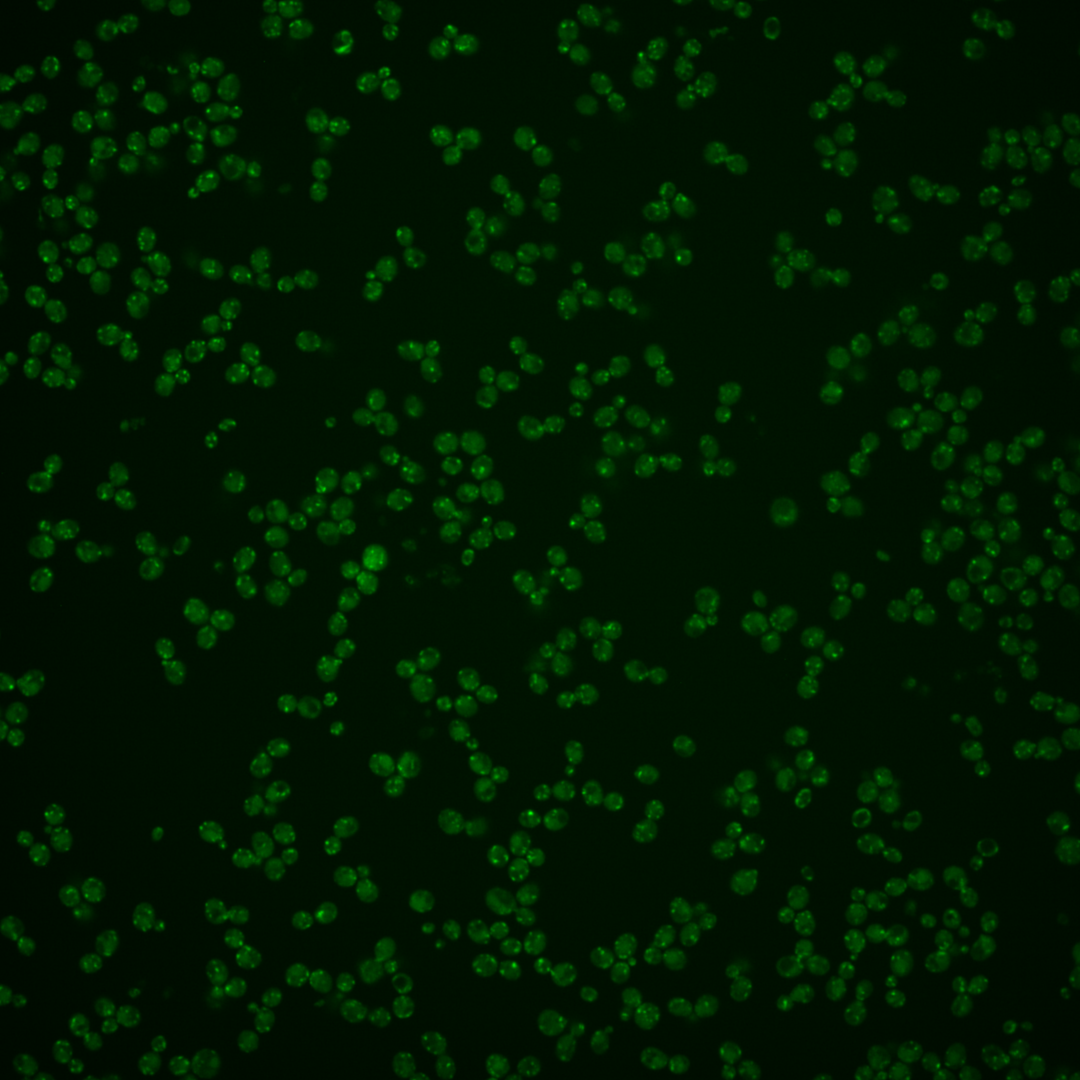
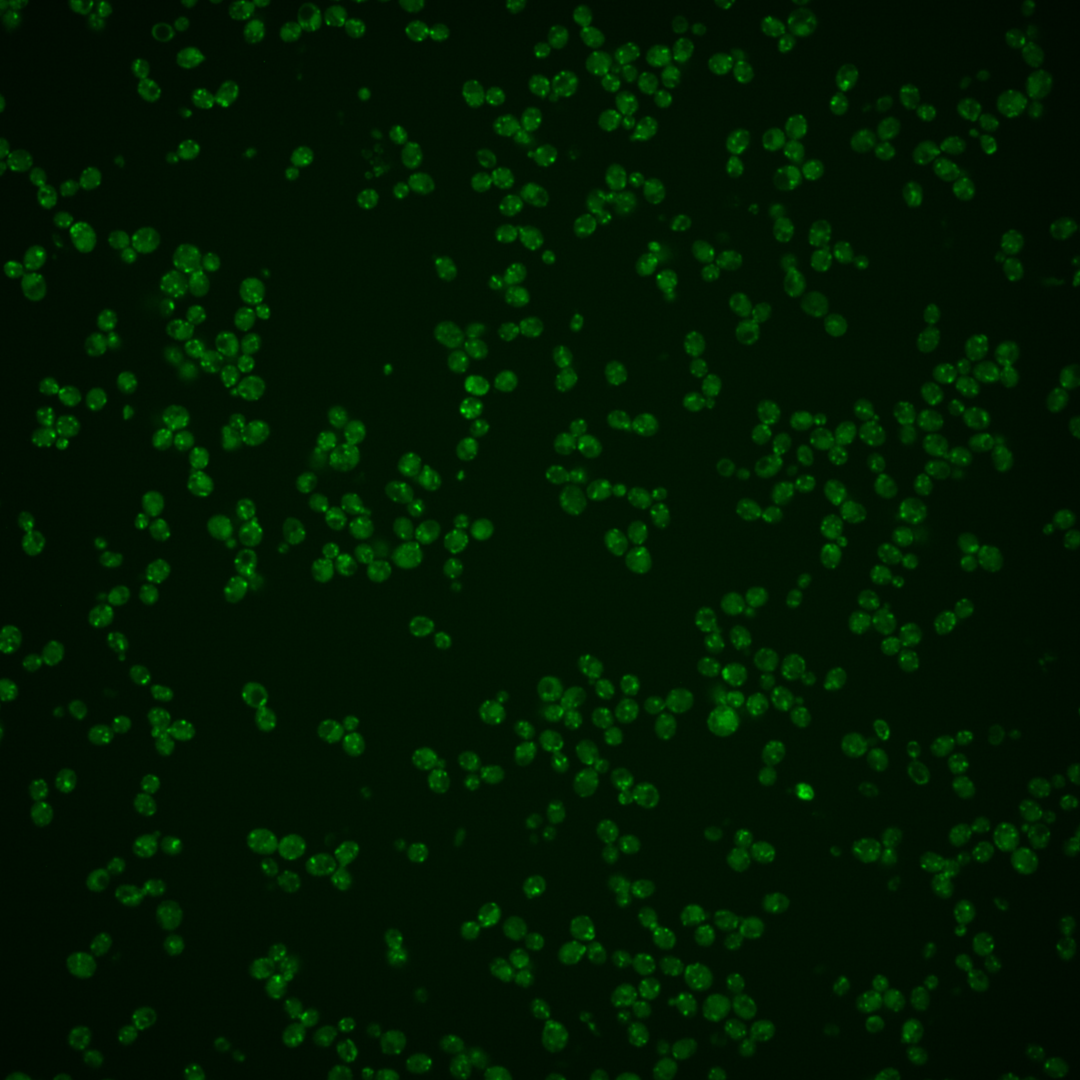

| Standard name | |
|---|---|
| Human Ortholog | |
| Description | Trans-golgi network aminophospholipid translocase (flippase); maintains membrane lipid asymmetry in post-Golgi secretory vesicles; contributes to clathrin-coated vesicle formation, endocytosis, protein trafficking between the Golgi and endosomal system and the cellular response to mating pheromone; autoinhibited by its C-terminal tail; localizes to the trans-Golgi network; mutations in human homolog ATP8B1 result in liver disease |
Micrographs




















































































Sub-cellular Localization
Yeast GFP Assignment
Protein Abundance
Localization Change
External localization resources
| ensLOC | DeepLoc | |||||||||||||||||||||||
|---|---|---|---|---|---|---|---|---|---|---|---|---|---|---|---|---|---|---|---|---|---|---|---|---|
| Localization | WT1 | WT2 | WT3 | RAP60 | RAP140 | RAP220 | RAP300 | RAP380 | RAP460 | RAP540 | RAP620 | RAP700 | HU80 | HU120 | HU160 | rpd3Δ_1 | rpd3Δ_2 | rpd3Δ_3 | WT1 | WT2 | WT3 | AF100 | AF140 | AF180 |
| Cortical Patches | 68 | 62 | 46 | 13 | 4 | 6 | 7 | 19 | 10 | 4 | 10 | 10 | 16 | 21 | 12 | – | 5 | – | 52 | 40 | 67 | 43 | 50 | 41 |
| Bud | 2 | 9 | 5 | 6 | 13 | 23 | 22 | 30 | 26 | 31 | 50 | 32 | 1 | 2 | 2 | – | 0 | – | 4 | 4 | 1 | 1 | 1 | 1 |
| Bud Neck | 0 | 0 | 0 | 0 | 0 | 0 | 0 | 0 | 0 | 0 | 0 | 0 | 0 | 0 | 0 | – | 0 | – | 0 | 0 | 0 | 0 | 0 | 0 |
| Bud Site | 0 | 0 | 0 | 0 | 1 | 5 | 7 | 7 | 6 | 2 | 14 | 12 | 0 | 0 | 0 | – | 0 | – | – | – | – | – | – | – |
| Cell Periphery | 1 | 2 | 3 | 1 | 3 | 1 | 7 | 2 | 1 | 1 | 3 | 0 | 0 | 1 | 0 | – | 0 | – | 0 | 0 | 0 | 0 | 0 | 0 |
| Cytoplasm | 16 | 15 | 10 | 15 | 15 | 14 | 14 | 18 | 8 | 15 | 10 | 8 | 7 | 10 | 7 | – | 5 | – | 2 | 3 | 1 | 1 | 2 | 0 |
| Endoplasmic Reticulum | 28 | 38 | 23 | 12 | 5 | 7 | 3 | 11 | 5 | 6 | 14 | 6 | 15 | 18 | 4 | – | 0 | – | 7 | 8 | 2 | 3 | 6 | 11 |
| Endosome | 36 | 5 | 37 | 26 | 52 | 16 | 47 | 40 | 4 | 6 | 6 | 12 | 6 | 14 | 13 | – | 2 | – | 78 | 44 | 60 | 33 | 28 | 34 |
| Golgi | 319 | 147 | 242 | 69 | 45 | 17 | 12 | 26 | 10 | 7 | 4 | 24 | 72 | 111 | 118 | – | 6 | – | 343 | 196 | 306 | 199 | 251 | 289 |
| Mitochondria | 185 | 142 | 222 | 196 | 220 | 422 | 589 | 615 | 401 | 452 | 530 | 511 | 30 | 28 | 27 | – | 3 | – | 7 | 8 | 11 | 11 | 13 | 14 |
| Nucleus | 2 | 2 | 0 | 0 | 0 | 0 | 0 | 3 | 4 | 3 | 0 | 3 | 1 | 0 | 1 | – | 0 | – | 0 | 0 | 0 | 0 | 0 | 0 |
| Nuclear Periphery | 1 | 1 | 4 | 4 | 2 | 4 | 6 | 10 | 5 | 7 | 10 | 12 | 0 | 0 | 0 | – | 0 | – | 0 | 1 | 1 | 0 | 0 | 1 |
| Nucleolus | 8 | 0 | 7 | 7 | 8 | 25 | 39 | 52 | 23 | 27 | 27 | 29 | 1 | 0 | 1 | – | 0 | – | 0 | 0 | 0 | 0 | 0 | 0 |
| Peroxisomes | 0 | 0 | 15 | 12 | 14 | 11 | 51 | 36 | 8 | 13 | 22 | 14 | 0 | 0 | 2 | – | 0 | – | 10 | 2 | 36 | 14 | 10 | 17 |
| SpindlePole | 1 | 0 | 5 | 2 | 3 | 8 | 11 | 12 | 2 | 3 | 5 | 5 | 0 | 2 | 3 | – | 0 | – | 3 | 1 | 1 | 1 | 2 | 1 |
| Vac/Vac Membrane | 26 | 8 | 9 | 4 | 8 | 6 | 22 | 12 | 3 | 14 | 3 | 10 | 4 | 15 | 16 | – | 0 | – | 12 | 10 | 4 | 2 | 3 | 3 |
| Unique Cell Count | 454 | 266 | 411 | 263 | 309 | 467 | 684 | 731 | 426 | 498 | 565 | 556 | 113 | 163 | 170 | 17 | 527 | 325 | 498 | 315 | 375 | 423 | ||
| Labelled Cell Count | 693 | 431 | 628 | 367 | 393 | 565 | 837 | 893 | 516 | 591 | 708 | 688 | 153 | 222 | 206 | 21 | 527 | 325 | 498 | 315 | 375 | 423 | ||
Yeast GFP Assignment
Protein Abundance
| Screen | WT1 | WT2 | WT3 | RAP60 | RAP140 | RAP220 | RAP300 | RAP380 | RAP460 | RAP540 | RAP620 | RAP700 | HU80 | HU120 | HU160 | rpd3Δ_1 | rpd3Δ_2 | rpd3Δ_3 | AF100 | AF140 | AF180 |
|---|---|---|---|---|---|---|---|---|---|---|---|---|---|---|---|---|---|---|---|---|---|
| Mean Cell GFP Intensity (1e-4) | 12.6 | 13.0 | 10.5 | 9.8 | 9.2 | 8.2 | 8.0 | 8.0 | 7.6 | 7.1 | 7.0 | 7.4 | 10.7 | 11.5 | 11.8 | – | 9.8 | – | 11.7 | 12.2 | 12.7 |
| Std Deviation (1e-4) | 1.8 | 2.2 | 1.7 | 1.7 | 1.8 | 1.7 | 1.8 | 1.8 | 1.7 | 1.5 | 1.7 | 1.8 | 2.0 | 2.0 | 2.2 | – | 2.2 | – | 1.8 | 1.8 | 1.8 |
| Intensity Change (Log2) | – | – | – | -0.1 | -0.2 | -0.37 | -0.4 | -0.4 | -0.48 | -0.57 | -0.59 | -0.51 | 0.02 | 0.12 | 0.17 | – | -0.1 | – | 0.15 | 0.21 | 0.27 |
Localization Change
| Localization | RAP60 | RAP140 | RAP220 | RAP300 | RAP380 | RAP460 | RAP540 | RAP620 | RAP700 | HU80 | HU120 | HU160 | rpd3Δ_1 | rpd3Δ_2 | rpd3Δ_3 |
|---|---|---|---|---|---|---|---|---|---|---|---|---|---|---|---|
| Cortical Patches | -2.8 | -5.2 | -6.2 | -7.6 | -6.0 | -5.1 | -6.8 | -6.2 | -6.2 | 0.9 | 0.6 | -1.5 | – | 0 | – |
| Bud | 0 | 2.5 | 3.1 | 2.1 | 2.7 | 3.7 | 3.9 | 5.1 | 3.6 | 0 | 0 | 0 | – | 0 | – |
| Bud Neck | 0 | 0 | 0 | 0 | 0 | 0 | 0 | 0 | 0 | 0 | 0 | 0 | – | 0 | – |
| Bud Site | 0 | 0 | 0 | 0 | 0 | 0 | 0 | 3.2 | 3.0 | 0 | 0 | 0 | – | 0 | – |
| Cell Periphery | 0 | 0 | 0 | 0 | 0 | 0 | 0 | 0 | 0 | 0 | 0 | 0 | – | 0 | – |
| Cytoplasm | 2.2 | 1.8 | 0.5 | -0.4 | 0 | -0.6 | 0.5 | -0.7 | -1.1 | 0 | 2.2 | 0 | – | 0 | – |
| Endoplasmic Reticulum | -0.6 | -2.7 | -3.3 | -5.4 | -3.9 | -3.6 | -3.7 | -2.5 | -4.1 | 2.8 | 2.3 | -1.7 | – | 0 | – |
| Endosome | 0.4 | 3.2 | -3.5 | -1.3 | -2.3 | -5.4 | -5.5 | -6.0 | -4.8 | -1.3 | -0.2 | -0.5 | – | 0 | – |
| Golgi | -8.3 | -12.0 | -17.9 | -21.7 | -21.2 | -17.8 | -19.3 | -20.7 | -18.8 | 0.9 | 2.0 | 2.4 | – | -1.9 | – |
| Mitochondria | 5.4 | 4.7 | 12.2 | 11.7 | 11.0 | 13.3 | 12.6 | 14.6 | 13.6 | -5.2 | -8.0 | -8.5 | – | -2.9 | – |
| Nucleus | 0 | 0 | 0 | 0 | 0 | 0 | 0 | 0 | 0 | 0 | 0 | 0 | – | 0 | – |
| Nuclear Periphery | 0 | 0 | 0 | 0 | 0.6 | 0 | 0 | 1.0 | 1.4 | 0 | 0 | 0 | – | 0 | – |
| Nucleolus | 0.9 | 0.8 | 2.9 | 3.2 | 4.0 | 2.9 | 2.9 | 2.6 | 2.9 | 0 | 0 | 0 | – | 0 | – |
| Peroxisomes | 0.6 | 0.6 | -1.1 | 2.6 | 1.0 | -1.6 | -0.9 | 0.2 | -1.0 | 0 | 0 | 0 | – | 0 | – |
| SpindlePole | 0 | 0 | 0.6 | 0.5 | 0.6 | 0 | 0 | 0 | 0 | 0 | 0 | 0 | – | 0 | – |
| Vacuole | -0.6 | 0.3 | -1.0 | 1.0 | -0.7 | -1.8 | 0.6 | -2.3 | -0.4 | 0 | 3.8 | 3.9 | – | 0 | – |
External localization resources
Images






























Protein Concentration and Protein Localization Data
| R1 | R2 | R3 | ||||||||||||||||
|---|---|---|---|---|---|---|---|---|---|---|---|---|---|---|---|---|---|---|
| G1 Pre-START | G1 Post-START | S/G2 | Metaphase | Anaphase | Telophase | G1 Pre-START | G1 Post-START | S/G2 | Metaphase | Anaphase | Telophase | G1 Pre-START | G1 Post-START | S/G2 | Metaphase | Anaphase | Telophase | |
| Concentration | 7.5376 | 8.7902 | 8.4782 | 8.0707 | 7.3575 | 8.242 | 8.0191 | 10.1815 | 9.9369 | 9.3654 | 8.3437 | 9.6294 | 10.8668 | 11.356 | 10.3221 | 9.9648 | 10.9148 | 10.1762 |
| Actin | 0.0621 | 0.0197 | 0.0178 | 0.0045 | 0.0301 | 0.0298 | 0.0583 | 0.035 | 0.0187 | 0.0109 | 0.0091 | 0.0277 | 0.0239 | 0.1267 | 0.0713 | 0.0166 | 0.0008 | 0.0534 |
| Bud | 0.0007 | 0.0008 | 0.0003 | 0.0001 | 0.0003 | 0.0002 | 0.0006 | 0.0001 | 0.0002 | 0.0002 | 0.0002 | 0.0002 | 0.0003 | 0.0003 | 0.0006 | 0.0001 | 0 | 0.0002 |
| Bud Neck | 0.0021 | 0.0008 | 0.0005 | 0.0003 | 0.0007 | 0.0008 | 0.0006 | 0.0003 | 0.0006 | 0.0007 | 0.0008 | 0.0006 | 0.0009 | 0.0006 | 0.0014 | 0.0004 | 0.0001 | 0.0012 |
| Bud Periphery | 0.0009 | 0.0004 | 0.0002 | 0.0001 | 0.0003 | 0.0002 | 0.0007 | 0.0001 | 0.0002 | 0.0001 | 0.0002 | 0.0002 | 0.0002 | 0.0002 | 0.0005 | 0.0001 | 0 | 0.0001 |
| Bud Site | 0.0068 | 0.008 | 0.0004 | 0.0002 | 0.0004 | 0.0003 | 0.0013 | 0.0009 | 0.0005 | 0.0004 | 0.0004 | 0.0002 | 0.0006 | 0.0024 | 0.0062 | 0.0004 | 0 | 0.0003 |
| Cell Periphery | 0.0003 | 0.0002 | 0.0001 | 0 | 0.0002 | 0.0001 | 0.0001 | 0 | 0.0001 | 0.0001 | 0.0001 | 0.0001 | 0.0001 | 0.0001 | 0.0002 | 0.0005 | 0 | 0.0001 |
| Cytoplasm | 0.0073 | 0.01 | 0.0023 | 0.0015 | 0.0027 | 0.0032 | 0.0021 | 0.0037 | 0.0014 | 0.0014 | 0.0016 | 0.002 | 0.0014 | 0.0304 | 0.0018 | 0.0117 | 0.0003 | 0.0012 |
| Cytoplasmic Foci | 0.1193 | 0.1633 | 0.0947 | 0.0883 | 0.0773 | 0.0733 | 0.0666 | 0.1583 | 0.1106 | 0.0838 | 0.1249 | 0.0633 | 0.1293 | 0.1755 | 0.1136 | 0.0903 | 0.069 | 0.065 |
| Eisosomes | 0.0003 | 0.0001 | 0.0001 | 0 | 0.0006 | 0.0001 | 0.0003 | 0 | 0.0003 | 0.0001 | 0 | 0.0001 | 0.0001 | 0.0001 | 0.0001 | 0.0001 | 0 | 0.0001 |
| Endoplasmic Reticulum | 0.0079 | 0.0026 | 0.0018 | 0.0005 | 0.002 | 0.0024 | 0.0019 | 0.0007 | 0.0004 | 0.0008 | 0.0014 | 0.002 | 0.0003 | 0.0072 | 0.0005 | 0.1055 | 0.0002 | 0.0006 |
| Endosome | 0.1968 | 0.2418 | 0.216 | 0.2763 | 0.2553 | 0.1985 | 0.1418 | 0.1917 | 0.1775 | 0.1326 | 0.2277 | 0.1562 | 0.1215 | 0.1225 | 0.1607 | 0.1863 | 0.1108 | 0.1322 |
| Golgi | 0.4134 | 0.4899 | 0.5639 | 0.5865 | 0.5818 | 0.6332 | 0.562 | 0.5505 | 0.6151 | 0.6974 | 0.5533 | 0.6918 | 0.5557 | 0.4588 | 0.5413 | 0.5519 | 0.809 | 0.709 |
| Lipid Particles | 0.0792 | 0.0262 | 0.0553 | 0.0173 | 0.0231 | 0.0241 | 0.0787 | 0.0441 | 0.0155 | 0.0543 | 0.0353 | 0.0159 | 0.0482 | 0.0202 | 0.0308 | 0.0257 | 0.0061 | 0.0131 |
| Mitochondria | 0.0289 | 0.0109 | 0.0164 | 0.0168 | 0.0107 | 0.0232 | 0.0247 | 0.0023 | 0.0251 | 0.0076 | 0.008 | 0.0201 | 0.0337 | 0.0054 | 0.0078 | 0.0031 | 0.0021 | 0.0062 |
| None | 0.0119 | 0.0001 | 0.0059 | 0 | 0.0019 | 0.0001 | 0.0027 | 0.0001 | 0.0001 | 0.0001 | 0.0001 | 0.0001 | 0.0001 | 0.0002 | 0.0005 | 0.0002 | 0 | 0 |
| Nuclear Periphery | 0.0124 | 0.0006 | 0.0013 | 0.0002 | 0.003 | 0.0008 | 0.0082 | 0.0002 | 0.0001 | 0.0003 | 0.0003 | 0.0004 | 0.0001 | 0.0026 | 0.0003 | 0.0017 | 0 | 0.0001 |
| Nucleolus | 0.0008 | 0.0005 | 0.0001 | 0 | 0.0001 | 0.0001 | 0.0011 | 0.0001 | 0 | 0 | 0 | 0 | 0.0001 | 0.0001 | 0.0004 | 0 | 0 | 0 |
| Nucleus | 0.004 | 0.0005 | 0.0003 | 0 | 0.0003 | 0.0002 | 0.0017 | 0.0001 | 0 | 0 | 0.0001 | 0.0001 | 0 | 0.0007 | 0.0003 | 0.0002 | 0 | 0 |
| Peroxisomes | 0.0306 | 0.0137 | 0.0164 | 0.0035 | 0.0039 | 0.0053 | 0.017 | 0.0097 | 0.032 | 0.0075 | 0.0333 | 0.016 | 0.0819 | 0.0433 | 0.0566 | 0.0025 | 0.001 | 0.0156 |
| Punctate Nuclear | 0.0071 | 0.0014 | 0.0025 | 0.0001 | 0.0015 | 0.0005 | 0.0259 | 0.0004 | 0.0002 | 0.0003 | 0.0006 | 0.0002 | 0.0004 | 0.0011 | 0.0032 | 0.0002 | 0 | 0.0001 |
| Vacuole | 0.0038 | 0.0068 | 0.0021 | 0.0014 | 0.0017 | 0.0016 | 0.0016 | 0.001 | 0.0006 | 0.0007 | 0.0011 | 0.0012 | 0.0005 | 0.0011 | 0.0011 | 0.0015 | 0.0001 | 0.0006 |
| Vacuole Periphery | 0.0032 | 0.0019 | 0.0019 | 0.0021 | 0.0023 | 0.0021 | 0.0021 | 0.0007 | 0.0007 | 0.0008 | 0.0014 | 0.0017 | 0.0007 | 0.0005 | 0.001 | 0.0011 | 0.0005 | 0.0009 |
Sequencing Data
| R1 | R2 | |||||||||
|---|---|---|---|---|---|---|---|---|---|---|
| G1 Post-START | S/G2 | Metaphase | Anaphase | Telophase | G1 Post-START | S/G2 | Metaphase | Anaphase | Telophase | |
| Gene Expression | 34.8543 | 21.0951 | 25.9092 | 32.4101 | 31.1232 | 24.3981 | 30.7067 | 30.6944 | 28.8487 | 39.0506 |
| Translational Efficiency | 0.4382 | 0.5653 | 0.5641 | 0.4582 | 0.4068 | 0.6291 | 0.4012 | 0.3507 | 0.3904 | 0.3473 |
Hit Data
| Dataset | Hit |
|---|---|
| Protein Concentration | ✘ |
| Protein Localization | ✔ |
| Gene Expression | ✘ |
| Translational Efficiency | ✘ |
Endocytosis
| Temp | Actin Patch (Sac6-tdTomato) | Cortical Patch (Sla1-GFP) | Late Endosome (Snf7-GFP) | Vacuole (Vph1-GFP) |
|---|---|---|---|---|
| 37℃ | ||||
| RT |
Cell Cycle Omics
CYCLoPs (Drs2-GFP)
| Gene / Allele | Actin Patch (Sac6-tdTomato) | Cortical Patch (Sla1-GFP) | Late Endosome (Snf7-GFP) | Vacuole (Sac6-tdTomato) |
|---|
| Gene | Images |
|---|
| Gene | Images |
|---|
Images are not yet available
Images are not yet available